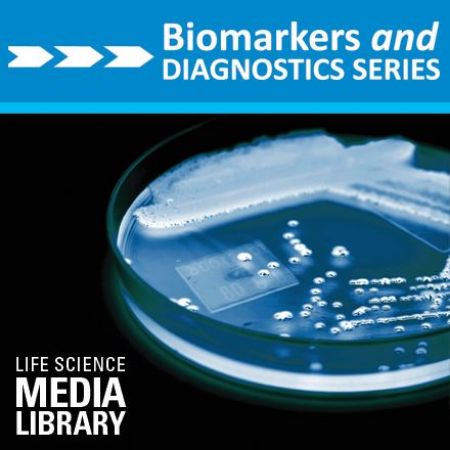
Picture for category Biomarkers & Diagnostics

You have no items in your shopping cart.
CDs
Advances In Prenatal Molecular Diagnostics - 2018 - CD
Advances In Prenatal Molecular Diagnostics - 2018 Cambridge, MA - CD
$350.00
Bio-IT World Conference and Expo - 2019 - CD
Bio-IT World Conference and Expo - 2019, April 16-18, Seaport World Trade Center, Boston, MA - CD
$750.00
BioIT World WEST 2020 - CD
BioIT World West 2020 Conference CD March 1-4, 2020 San Francisco, CA
$750.00
Biomarkers & Diagnostics World Congress 2016 - CD
Biomarkers & Diagnostics World Congress Complete Content - 2016
$750.00
Biomarkers & Immuno-Oncology World Congress 2018 - CD
Complete CD of Biomarkers & Immuno-Oncology World Congress presentations
$750.00
Biotherapeutics Analytical Summit 2020 - CD
Biotherapeutics Analytical Summit 2020 - CD June 1-5, 2020 Alexandria Virginia
$750.00
Bispecific Antibody Pipeline Congress - 2018 - CD
Bispecific Antibody Pipeline Congress - August 20-23, 2018 - CD
$750.00